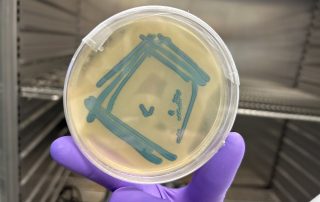

Uppdrag: Säkra rent dricksvatten i kris
Med hjälp av resurssmarta förpackningar och innovativa affärsmodeller vill skånska Aqua Nobel säkra Sveriges tillgång på dricksvatten i kris och i värsta fall krig.
– Utan rent vatten fungerar ingenting, säger vd Pontus Klenell till Livsmedel i fokus.